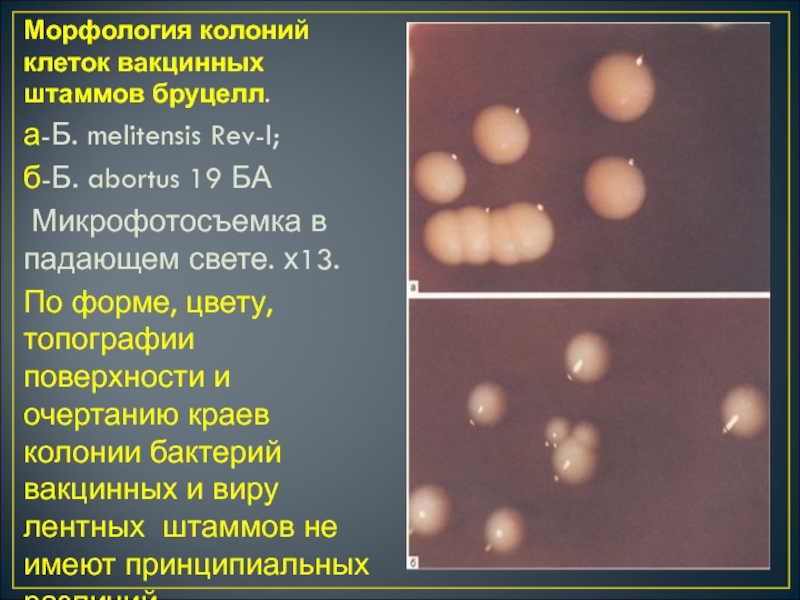
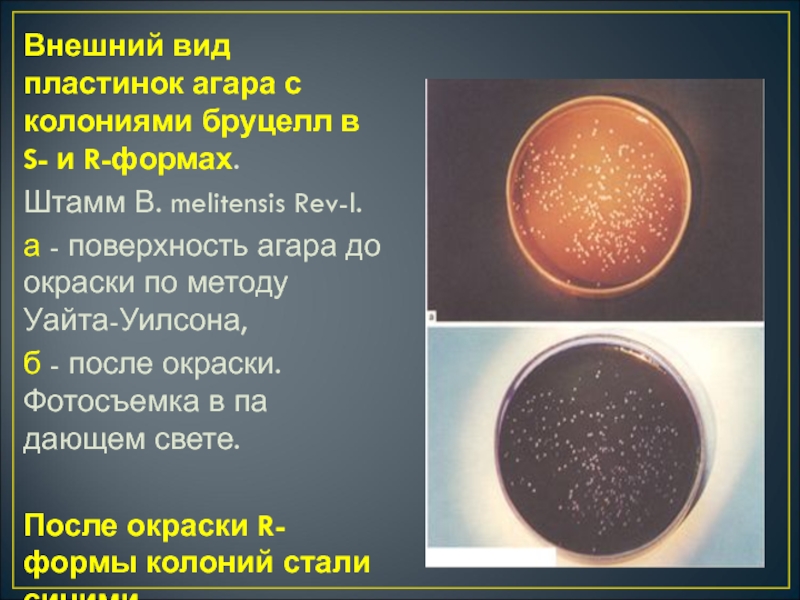

Разделы презентаций
- Разное
- Английский язык
- Астрономия
- Алгебра
- Биология
- География
- Геометрия
- Детские презентации
- Информатика
- История
- Литература
- Математика
- Медицина
- Менеджмент
- Музыка
- МХК
- Немецкий язык
- ОБЖ
- Обществознание
- Окружающий мир
- Педагогика
- Русский язык
- Технология
- Физика
- Философия
- Химия
- Шаблоны, картинки для презентаций
- Экология
- Экономика
- Юриспруденция
Электронное пособие по возбудителю бруцеллеза для ПЗ, СРСП и СРС
Содержание
- 1. Электронное пособие по возбудителю бруцеллеза для ПЗ, СРСП и СРС
- 2. БРУЦЕЛЛЕЗ - инфекционное заболевание животных и человека,
- 3. История Бруцеллез имеет древнюю историю. Но документальные
- 4. Морфология бруцеллМелкие Грам (-) коккобактерии, не имеющие спор и жгутиков;при определенных условиях образуют микрокапсулу
- 5. Классификация бруцелл:Возбудитель бруцеллеза относитсяК роду: BrucellaВиды: B.
- 6. Слайд 6
- 7. Микроскопическая картина клеток возбудителей бруцеллеза в окрашенных
- 8. Прижизненная микроскопическая картина бруцелл, выращенных на FГ
- 9. Внешний вид клеток В. melitensis 16 М
- 10. Субмикроскопическое строение клеток В. melitensisа, б, г, д - х60 000; в, е - х80 000
- 11. Внешняя мембрана трехслойная (а, б, В, е).
- 12. Ультраструктура бруцелл при делении. а- закладка перетяжки;
- 13. Слайд 13
- 14. Антигены бруцелл:Соматические видоспецифическиеА- (преобладает уB. suis и
- 15. КУЛЬТИВИРОВАНИЕ: СТРОГИЕ АЭРОБЫРАСТУТ НА ПЕЧЕНОЧНЫХ СРЕДАХ С
- 16. Морфология микроколоний бруцелл, выращенных в течение 36
- 17. Внешний вид пластинок агара с колониями бруцелл,
- 18. Морфология колоний клеток вирулентных штаммов возбудителей бруцеллеза.
- 19. Морфология колоний клеток вакцинных штаммов бруцелл. а-Б.
- 20. Внешний вид пластинок агара с колониями бруцелл
- 21. Морфологические особенности S- и R-Форм колоний бруцелл,
- 22. Инагглютинабельные культуры бруцелл
- 23. ФЕРМЕНТАТИВНЫЕ СВОЙСТВА:В ОТНОШЕНИИ УГЛЕВОДОВ МАЛОАКТИВНЫ, БЕЛКИ НЕ
- 24. ЭПИДЕМИОЛОГИЯ: ВОСПРИИМЧИВ МЕЛКИЙ РОГАТЫЙ СКОТ (козы, овцы),
- 25. Основные хозяева различных бруцелл: B.melitensis – овцы,
- 26. Входные ворота инфекции при бруцеллезе:Слизистая пищеварительного тракта, поврежденная кожа
- 27. Сырое молоко и мясо могут быть источником бруцеллеза
- 28. Патогенез Бруцеллеза
- 29. Особенности патогенеза бруцелл:Размножение и персистирование бруцелл в
- 30. Сроки развития ГЗТ при бруцеллезе:Конец первого месяца
- 31. Слайд 31
- 32. Инкубационный период бруцеллеза составляет от 6 до
- 33. Слайд 33
- 34. КЛИНИКА:УНДУЛИРУЮЩАЯ (волнообразная) ЛИХОРАДКА (ЧИСЛО ВОЛН ДО
- 35. Иммунитет:Непрочный, непродолжительный, сохраняется в течении 6-9 мес.Нередки
- 36. Профилактика бруцеллеза-Комплекс ветеринарно – санитарных , хозяйственных
- 37. Принципы лабораторной диагностики бруцеллеза:Обнаружение возбудителя и его
- 38. Материалы для исследования:От людей:КровьКостный мозгСМЖМочаЖелчьСуставная жидкость( при
- 39. Материалы для исследования:Пищевые продукты:СливкиСырыТворогмясоОбъекты внешней среды:ВодаПочванавоз
- 40. Способы сбора клинического материалаКровь для гемокультуры –
- 41. Критерии дифференцирования видов бруцелл в бактериологическом методе:Продукция
- 42. Реакции, используемые для обнаружения антител при бруцеллезе:Реакция
- 43. Реакция Райта Постановка реакции Райта проводится с целью
- 44. Схема постановки реакции Райта
- 45. Реакция Райта наибольшую диагностическую ценность представляет при
- 46. реакция ХеддльсонаРеакция ставится при массовом обследовании на
- 47. Пластинчитая реакция агглютинации (реакция Хеддльсона)Преимущество – простота
- 48. Учет реакции:В случае (+) реакции с первых
- 49. Слайд 49
- 50. Серологические реакции:Антиглобулиновая проба (реакция Кумбса), выявляющая неполные
- 51. Аллергический методДля выявления сенсибилизации при бруцеллезе применяется
- 52. Биологический метод:Его применяют одновременно с бактериологическим методомДля
- 53. Непрямой иммунофлюоресиентный метод (нРИФ)Непрямой иммунофлюоресиентный метод (нРИФ).
- 54. Аллергический методВнутрикожная аллергическая проба Бюрне. Проба основана
- 55. Опсоно-фагоцитарная реакция (ОФР).Проба основана на способности полинуклеарных
- 56. Реакция лизиса лейкоцитовоснована на учете разрушения лейкоцитов
- 57. Полимеразная цепная реакция (ПЦР). Используют для определения
- 58. Серологические реакции и аллергическая кожная проба в
- 59. Слайд 59
- 60. Слайд 60
- 61. ВКЛЮЧИТЕ ВИДЕО И ОТДОХНИТЕ!!!
- 62. Brucella: - Gram-Negative Intracellular (STRUCTURE) (
- 63. (DISEASES) Undulant fever (ЕРIDЕМIOLОGУ)Transmitted in unpasteurized dairy
- 64. Thank you for the work labor!!!
- 65. Скачать презентанцию
Слайды и текст этой презентации
Слайд 2БРУЦЕЛЛЕЗ - инфекционное заболевание животных и человека, характеризующееся острым и
подострым хроническим течением. Сопровождается лихорадкой, поражением селезенки, печени, половых органов;
нервной, сердечной и костных систем.1886 г. - Брюс на о. Мальта (обнаружил в селезенке умершего человека). Мальтийская лихорадка.
Слайд 3История
Бруцеллез имеет древнюю историю. Но документальные данные об этом
заболевании впервые появились в шестидесятых годах девятнадцатого столетия. Первым описал
эту болезнь британский военный медик Мэрстон. Уже через двадцать лет после первого описания появилось и второе. Его сделал также Британский военный медик Брюс, работавший на Мальте. Он провел лабораторные исследования внутренних органов пациента, умершего от этого заболевания (тогда его называли еще мальтийской лихорадкой). В селезенке был найден микроорганизм, получивший название бруцеллы. Уже через двенадцать месяцев этот выдающийся ученый сам научился выращивать бруцеллы в условиях лаборатории.Слайд 4Морфология бруцелл
Мелкие Грам (-) коккобактерии,
не имеющие спор и жгутиков;
при
определенных условиях образуют микрокапсулу
Слайд 5Классификация бруцелл:
Возбудитель бруцеллеза относится
К роду: Brucella
Виды:
B. melitensis (козье-овечий)
B. suis
(свиной)
B. abortus (коровий)
B. Canis (собачий)
B. Ovis (баранов)
B. Neotomae ( кустарниковых
крыс)Слайд 7Микроскопическая картина клеток возбудителей бруцеллеза в окрашенных мазках культур, выращенных
в эритрит-агаре в течение 72 ч.
а-В. melitensis 16 М;
В. abortus 544;в-В. suis Окраска по Граму. x1l50.
Слайд 8Прижизненная микроскопическая картина бруцелл, выращенных на FГ -агаре в течение
72 ч.
а, в-В. melitensis 16 М; б - В.
abortus 544. Иммобилизация клеток агаровым (а, б) и желатиновым (в) гелями. Аноптральный контраст. х1350. По морфологии микробы довольно однородные и представлены кокками, овоидами инебольшими прямыми палочками (а, б, в). Протоплазма живых клеток по цвету темнее фона поля зрения и не содержит включений. Их клеточная оболочка на всем протяжении равномерной оптической плотности и толщины (в).
Слайд 9Внешний вид клеток В. melitensis 16 М при электронной микроскопии.
Контрастирование уранилацетатом. х20 000.
- поверхность клеток покрыта аморфными материалами,
интенсивно контрастируемыми уранилацетатом; б - при значительном развитии такой покров напоминает капсулу . Слайд 11Внешняя мембрана трехслойная (а, б, В, е). Возможно слияние ее
с базальной мембраной пептидогликана (б, г, е), периплазма значительных (б)
и небольших размеров (В), может быть заполнена материалом высокой (б) и средней (а, г плотности по отношению к электронам или почти электронно-прозрачной (д, е). Рибосомы и полисомы плотно упа кованные (а, в). Нуклеоид представлен небольшими зонами нуклеоплазмьr (а-г). Включения располагаются в цитоплазме (б) или пери плазме (г).Слайд 12Ультраструктура бруцелл при делении.
а- закладка перетяжки;
б, в -
углубление ее. В зоне деления могут располагаться включения (б).
Слайд 14Антигены бруцелл:
Соматические видоспецифические
А- (преобладает уB. suis и B. abortus
М-
антигены (преобладает у B. melitensis );
Термостабильный Vi - антиген
Основные факторы
патогенности бруцелл:Эндотоксин
Гиалуронидаза
Низкомолекулярные вещества, подавляющие фагоцитоз
адгезины
Слайд 15КУЛЬТИВИРОВАНИЕ:
СТРОГИЕ АЭРОБЫ
РАСТУТ НА ПЕЧЕНОЧНЫХ СРЕДАХ С ДОБАВЛЕНИЕМ АМИНОКСИЛОТ, ВИТАМИНОВ, КАЗЕИНА,
СЫВОРОТКИ КРОВИ
РОСТ ЗАМЕДЛЕН (30 СУТ), при пересевах растет быстрее
Br .
abortus НУЖДАЕТСЯ В 5-10% СО2КОЛОНИИ МЕЛКИЕ, БЕСЦВЕТНЫЕ С ПЕРЛАМУТРОВЫМ ОТТЕНКОМ
НА ПЕЧЕНОЧНОМ БУЛЬОНЕ – МУТЬ.
Слайд 16Морфология микроколоний бруцелл, выращенных в течение 36 ч на FГ-aгape.
а- B.melitensis 16m; б- В. abortus 544; в- B. suis
1300.Микрофотосъемка проходящем свете. х56.
Микроколонии по внешне виду напоминают полусферу с гладкой поверхностью и ровными краями. На вершине микроколоний В. melitensis возможны округлые зоны центрального роста.
Слайд 17Внешний вид пластинок агара с колониями бруцелл, выращенных в течение
72 ч на FГ -агаре.
a- В. melitensis 16
М; б-В. abortus 544; в-В. suis 1300. Фотосъемка в падающем свете. По форме, цвету и консистенции колонии бруцелл сопоставляемых штаммов практически не отличаются
Слайд 18Морфология колоний клеток вирулентных штаммов возбудителей бруцеллеза.
а-В. melitensis 16
М;
б - В. abortus 544;
в-В. suis 1300. Микрофотосъемка в
падающем свете. х13.Независимо от ВИДОВЫХ особенностей бруцеллы образуют белые колонии в форме полусферы с ровными краями и гладкой блестящей поверхностью, отражающей лучи света (а-в).
Слайд 19Морфология колоний клеток вакцинных штаммов бруцелл.
а-Б. melitensis Rev-l;
б-Б.
abortus 19 БА
Микрофотосъемка в падающем свете. х13.
По форме,
цвету, топографии поверхности и очертанию краев колонии бактерий вакцинных и вирулентных штаммов не имеют принципиальных различий. Слайд 20Внешний вид пластинок агара с колониями бруцелл в S- и
R-формах.
Штамм В. melitensis Rev-l.
а - поверхность агара до
окраски по методу Уайта-Уилсона, б - после окраски. Фотосъемка в падающем свете.
После окраски R-формы колоний стали синими.
Слайд 21Морфологические особенности S- и R-Форм колоний бруцелл, окрашенных по методу
Уайта-Уилсона.
Микрофотосъемка в падающем свете. хз.
а - полное прокрашивание;
б
- частичное. Гладкие колонии остаются белыми, а R-формы прокрашиваются полностью или частично.
Слайд 23ФЕРМЕНТАТИВНЫЕ СВОЙСТВА:
В ОТНОШЕНИИ УГЛЕВОДОВ МАЛОАКТИВНЫ,
БЕЛКИ НЕ РАСЩЕПЛЯЮТ
ДЛЯ ДИФФЕРЕНЦИАЦИИ БРУЦЕЛЛ
ПРИМЕНЯЮТ:
1.бактериостатическое действие красок
2. потребность в СО2
3. образование сероводорода
4. РА с
монорецепторными сыворотками.РЕЗИСТЕНТНОСТЬ:
ЗНАЧИТЕЛЬНО УСТОЙЧИВЫ В ПИЩЕВЫХ ПРОДУКТАХ:
МОЛОКО - несколько недель
МЯСО- 20 сут
МАСЛО- до 60 дней
СЫР- до 4 недель
НА БЕЛЬЕ в выделениях- до 1 мес
В ПЫЛИ, ВОДЕ- до 2 мес
КИПЯЧЕНИЕ – мгновенно, 60оС-30 мин
к ДЕЗИНФЕКТАНТАМ – УСТОЙЧИВ.
Слайд 24ЭПИДЕМИОЛОГИЯ:
ВОСПРИИМЧИВ МЕЛКИЙ РОГАТЫЙ СКОТ (козы, овцы), КРС (свиньи, лошади, коровы),
грызуны, лаб. животные
-ЗАРАЗНЫМ ЯВЛЯЮТСЯ выделения больных животных - моча, околоплодные
воды, молоко (особенно молочные продукты), мясо.Наиболее опасный для человека источник заражения бруцеллезом: мелкий рогатый скот, а при миграции бруцелл овечьего типа - коровы
Слайд 25Основные хозяева различных бруцелл:
B.melitensis – овцы, козы
B.suis – свиньи,
зайцы, северный олень
B.abortus - КРС
B.canis – собаки
Наиболее патогенный для человека
вид бруцелл - B. melitensisВид бруцелл, который чаще вызывает бессимптомную инфекцию - B. abortus
Слайд 29Особенности патогенеза бруцелл:
Размножение и персистирование бруцелл в макрофагах ( кровь,
селезенка, костный мозг, лимфатические узлы)
Длительная до года и более бактериемия
Развитие
ГЗТВозможность формирования бессимптомной инфекции (скрытая форма инфекции)
Хр. Течение с поражением кроветворной, нервной, половой систем, суставов.
Слайд 30Сроки развития ГЗТ при бруцеллезе:
Конец первого месяца от момента инфицирования
Длительность
выявления ГЗТ:
ГЗТ сохраняется в течении всего инфекционного процесса и многие
годы после его прекращенияСлайд 32Инкубационный период бруцеллеза составляет от 6 до 30 дней.
У
некоторых пациентов данное заболевание протекает в острой форме, у других
возникает первично-латентная форма без клинических признаков.Существуют еще первично и вторично - хронические метастатические формы. У больных с остросептической формой заболевания температура повышается до 40 °С, при этом , следует отметить то , что самочувствие остается хорошим.
При бруцеллезе характерны: умеренная головная боль, ломящие боли во всем теле, повышенная потливость. Наблюдается микрополиаденит, увеличивается печень и селезенка. Часто, при хронических формах возникают различные изменения органов. Поражаются крупные суставы (артриты, периартриты), переферическая нервная система, мышцы. Существует возможность возникновения орхоэпидимитов, эндометритов, орхитов.
Одним из самых негативных последствий, является - самопроизвольный аборт.
При бруцеллезе обострения сменяются ремиссиями, это довольно долгосрочный процесс. У некоторых пациентов происходят стойкие остаточные явления. Это резидуальный бруцеллез.
При диагностики заболевания необходимо учитывать контакт с инфицированными животными. Также немаловажное значение уделяется эпидемиологическим предпосылкам.
Слайд 34 КЛИНИКА:
УНДУЛИРУЮЩАЯ (волнообразная) ЛИХОРАДКА (ЧИСЛО ВОЛН ДО 15 И БОЛЕЕ)
-ПОСТЕПЕННЫЙ
ПОДЪЕМ ТЕМПЕРАТУРЫ ДО 38-39С
-потливость, увеличение л/у, печени, селезенки, боли в
мышцах, суставах, в пояснице, тазовых костях, по ходу седалищного нерва-заболевание протекает в виде ТИПИЧНОЙ ХРОН. РЕЦИДИВИРУЮЩЕЙ ИНФЕКЦИИ И БЕССИМПТОМНО.
Слайд 35Иммунитет:
Непрочный, непродолжительный, сохраняется в течении 6-9 мес.
Нередки случаи повторного заболевания
людей бруцеллезом.
Иммунитет при бруцеллезе обусловлен клеточным (фагоцитоз); гуморальными (агллютинины,
комплементсвязывающие антитела) факторами, сочетается с аллергиейСпецифическая профилактика бруцеллеза: вакцина бруцеллезная живая применяется по эпидпоказаниям
Вакцину против бруцеллеза используют как для вакцинации животных, так и для лечения зараженных людей
Специфическое лечение хронического бруцеллеза: бруцеллезный иммуноглобулин;
вакцина бруцеллезная лечебная (убитая)-редко
Препараты для химиотерапии: антибиотики широкого спектра действия
.
Слайд 36Профилактика бруцеллеза
-Комплекс ветеринарно – санитарных , хозяйственных и медико-санитарных мероприятий.
В
основе - меры профилактики инфекции среди животных и ликвидация
очагов эпизотии в случае их возникновения.Слайд 37Принципы лабораторной диагностики бруцеллеза:
Обнаружение возбудителя и его Аг
Специфических Ат
Сенсибилизации организма
к бруцеллезным Аг
Выявление специфических изменений в организме
Основные методы лабораторной диагностики:
Бактериологический
(выделение гемо-, урино-, копрокультур)Серологический
Биологический
Аллергический
Слайд 38Материалы для исследования:
От людей:
Кровь
Костный мозг
СМЖ
Моча
Желчь
Суставная жидкость( при артритах)
Гной (при абсцессах)
Секционный
материал
От животных:
Абортированные плоды
Плодные оболочки или желудок плода с его содержимым
Лимф.узлы
Влагалищные
выделениямолоко
Слайд 39Материалы для исследования:
Пищевые продукты:
Сливки
Сыры
Творог
мясо
Объекты внешней среды:
Вода
Почва
навоз
Слайд 40Способы сбора клинического материала
Кровь для гемокультуры – берут из локтевой
вены,10мл, стерильно
Кровь для серологии – берут из пальца 1-2 мл
Моча-
берут стерильным катетером в стерильную посудуГрудное молоко – собирают в стерильную посуду
СМЖ – специальной иглой в стерильную посуду
Костный мозг – стерильным шприцем в стерильную посуду
Слайд 41Критерии дифференцирования видов бруцелл в бактериологическом методе:
Продукция сероводорода
Рост на средах
с анилиновым красителем (основной фуксин, и тионин)
Агглютинация с монорецепторными сыворотками
против А-, М-антигеновЧувствительность к фагу
Окисление субстратов (аминокислоты, углеводы, спирты)
Слайд 42Реакции, используемые для обнаружения антител при бруцеллезе:
Реакция агглютинации (Хеддельсона –
на стекле; Райта – пробирках)
Опсонофагоцитарная
РПГА, РСК, реакция Кумбса, ИФА
Слайд 43Реакция Райта
Постановка реакции Райта проводится с целью определения содержания в
сыворотке крови больного специфичных антител.
Компоненты реакции:
а. исследуемая сыворотка
в разведении 1:25; б. антиген - взвесь убитых бруцелл (диагностикум Райта).
Слайд 45Реакция Райта наибольшую диагностическую ценность представляет при острой и подострой
формах бруцеллеза.
Учет результатов проводится через 18-20 часов.
Учет реакции проводят
по стандарту мутности в зависимости от степени осаждения агглютината и просветления жидкости.Диагностическим титром принято считать РА не менее 2+ при разведении сыворотки 1: 100 и выше.
Слайд 46реакция Хеддльсона
Реакция ставится при массовом обследовании на бруцеллез с использованием
стеклянных пластин.
Компоненты реакции:
А - неразведенная сыворотка крови больного
В – антиген
– взвесь убитых и окрашенных кристалл-виолетом бруцеллСлайд 47Пластинчитая реакция агглютинации (реакция Хеддльсона)
Преимущество – простота постановки реакции
В качестве
Аг в реакциях Райта и Хеддльсона –единый бруцеллезный диагностикум
Реакцию ставят
на обычном стекле, расчерченном на квадраты величиной 4х4 см каждый, 5 квадратов по горизонтали.На 1-м квадрате с левой стороны записываю № испытуемой сыворотки, в последующие квадраты слева направо разливают испытуемую сыворотку в дозах данных в таблице.
К последней дозе сыворотки добавляют 0, 03 мл изотонического раствора хлорида натрия. Сыворотку осторожно смешивают с Аг палочкой, начиная с минимальной дозы (!). Контроль Аг –ставят р-р хлорида натрия с Аг. Затем слегка подогревают над пламенем спиртовки так, чтобы происходило равномерной нагревание всей поверхности стекла.
Слайд 48Учет реакции:
В случае (+) реакции с первых минут в каплях
сыворотки с Аг появляются хлопья агглютината.
Максимальный срок наблюдения- 8 минут.
Учет
реакции проводят невооруженным глазом:За (+) результат принимают агглютинацию не менее 2+ (незначительное просветление жидкости с заметными хлопьями – 50% агглютинации) во всех дозах сыворотки.
Слайд 50Серологические реакции:
Антиглобулиновая проба (реакция Кумбса), выявляющая неполные антитела, используется в
диагностике бруцеллеза у людей и животных, особенно при хроническом течении
инфекции, когда РА может быть отрицательной или положительной в низких титрах.РНГА является специфичным и высокочувствительным методом выявления бруцеллезных антител в сыворотке крови человека. Для постановки РИГА используют бруцеллезный эритроцитарный антигенный диагностикум.
ИФА применяют для диагностики всех форм заболевания, а также при эпидемиологическом обследовании населения и при отборе лиц для вакцинации против бруцеллезной инфекции.
Слайд 51Аллергический метод
Для выявления сенсибилизации при бруцеллезе применяется препарат бруцеллин
Химический состав
бруцеллина – протеиновый экстракт культур бруцелл
Положительная аллергическая реакция (проба Бюрне)
при бруцеллезе бывает при болезни, перенесенном в прошлом; вакцинации; скрытой инфекции.Слайд 52Биологический метод:
Его применяют одновременно с бактериологическим методом
Для постановки биопробы используются
- морские свинки, белые мыши.
Животных заражают внутрибрюшинно. Вскрывают: свинок на
30-35 сут; мышей на 20-25 сут после заражения.Бактериологическим методом исследуют л/узлы, печень, селезенку.
Перед посевом кусочки ткани тщательно растирают в ступке поскольку бруцеллы находятся внутриклеточно
Слайд 53Непрямой иммунофлюоресиентный метод (нРИФ)
Непрямой иммунофлюоресиентный метод (нРИФ).
Заранее готовят мазки
из 1-2-суточной агаровой культуры возбудителя (1 х 109 мк/мл), фиксируют
их в этиловом спирте в течение 30 мин, высушивают на воздухе и помещают во влажную камеру.В качестве контролей служат препараты бруцелл, обработанные бруцеллезной сывороткой (положительный контроль) и сыороткой, не содержащей антитела к бруцеллам (отрицательный контроль).
Реакцию учитывают путем просмотра препарата в люминесцентном микроскопе. Диагностическим считается титр не менее 1 :4.
Слайд 54Аллергический метод
Внутрикожная аллергическая проба Бюрне.
Проба основана на способности организма,
сенсибилизированного бруцеллезным антигеном, отвечать специфической местной реакцией на внутрикожное введение
бруцеллина (фильтрат 3-недельной культуры бруцелл) в дозе О,] мл В ладонную поверхность предплечья.Реакция учитывается через 24-48 ч по размеру отека в сантиметрах.
При наличии на месте введения отека не более 2 см в диаметре проба считается слабоположительной, 2-6 см - положительной, свыше 6 см - резко положительной.
Гиперемию кожи при отсутствии отека принимают за отрицательный результат.
Введение специфического антигена в сенсибилизированный организм небезразлично для обследуемого. В связи с этим заслуживают внимания эффективные методы выявления ГЗТ методом in vitro.
Слайд 55Опсоно-фагоцитарная реакция (ОФР).
Проба основана на способности полинуклеарных нейтрофилов крови зараженного
бруцеллезом организма фагоцитировать бруцеллы in vitro.
В пробирку, содержащую 0,2
мл 2 % раствора цитрата натрия, добавляют 0,4 мл исследуемой сыворотки и 0,2 мл специального антигена дЛЯ ОФР (4 х 109 клеток убитых нагреванием бруцелл в 1 мл изотонического раствора натрия хлорида). Содержимое пробирок перемешивают и 30 мин инкубируют в термостате при 37 ОС. Затем из содержимого пробирок готовят мазки, как для подсчета лейкоцитов, фиксируют их и окрашивают по Козловскому или синькой Мансона.
Учет результатов про изводят путем подсчета количества фагоцитированных одним нейтрофилом бруцелл в учтенных подряд 25 нейтрофильных полинуклеарах.
У здоровых людей фагоцитарный индекс в отношении бруцелл равен 0-5. Фагоцитарный индекс 10-24 характеризует слабовыраженную реакцию.
Слайд 56Реакция лизиса лейкоцитов
основана на учете разрушения лейкоцитов сенсибилизированного организма под
влиянием специфического антигена, обладает строгой специфичностью, позволяет получить ответ в
короткие сроки - через 3-4 ч после взятия крови.Реакцию проводят в пробирках из химически чистого стекла. В качестве антигена используют взвесь убитых нагреванием бруцелл (вакцинный штамм В. abortus 19ВА) в концентрации 1 х 107 мк/мл. Кровь для исследования берут в количестве 1 мл и вносят в колбочку с гепарином из расчета 75-80 МЕ гепарина на 1 мл крови. В две пробирки переносят по 0,4 мл гепаринизированной крови. В первую пробирку добавляют 0,1 мл бруцеллезного антигена (опытная пробирка), во вторую - 0,1 мл изотонического раствора натрия хлорида (контрольная пробирка). Пробирки встряхивают в течение 2-3 мин и проводят подсчет лейкоцитов в камере Горяева. Затем пробирки инкубируют в термостате в течение 2 ч при 37 ос, периодически встряхивая. После инкубации пробирки вновь встряхивают в течение 2-3 мин и проводят подсчет лейкоцитов. Подсчет производят 2- 3-кратно для каждой пробирки, затем выводится средний показатель. Вычисляют процент лейкоцитов после инкубации к исходному количеству для опытной и контрольной пробирок.
Показатель специфического лизиса лейкоцитов подсчитывают путем определения разницы между про центом уменьшения лейкоцитов в опытной пробирке и процентом уменьшения лейкоцитов в контроле.
Он выражается отрицательной величиной и колеблется в пределах от -10 до -30 %. Показатель меньше -10 % свидетельствует о неспецифическом лизисе.
Слайд 57Полимеразная цепная реакция (ПЦР).
Используют для определения ДНК бруцелл в
различных объектах ПЦР.
При диагностике бруцеллеза у людей ДНК определяют
в сыворотке крови, спинномозговой и синовиальной жидкости и др. При оценке результатов ПЦР следует учитывать, что специфический праймер считается родовым и выявляет ДНК всех видов бруцелл, включая и вакцинные штаммы. Это особенно важно для эндемичных по бруцеллезу регионов, в которых для вакцинации животных используют живые бруцеллезные вакцины, которыми может быть инфицирован и обслуживающий персонал.
Слайд 58Серологические реакции и аллергическая кожная проба в различные периоды заболевания
по своему диагностическому значению не равноценны и не могут заменять
друг друга.Наиболее надежным способом диагностики бруцеллеза является применение комплексного сероаллергического метода.
В ранние сроки от начала заболевания диагностическая ценность серологического метода выше аллергического; серологические реакции в этот период положительны почти в 98 % случаев. По мере удлинения срока заболевания процент положительных серологических реакций (РА, РНГА) начинает падать.
В поздние периоды заболевания большую диагностическую ценность имеют реакция Кумбса, ИФА и внутрикожная аллергическая проба.
Слайд 62Brucella: - Gram-Negative Intracellular
(STRUCTURE) ( - )
Gram-negative coccobacillus
(LАВ
ID)
Cultured from bIood, slow growth оn bIood agar, serology
(
VIRULENCE FACTORS )Intracellular growth, LPS